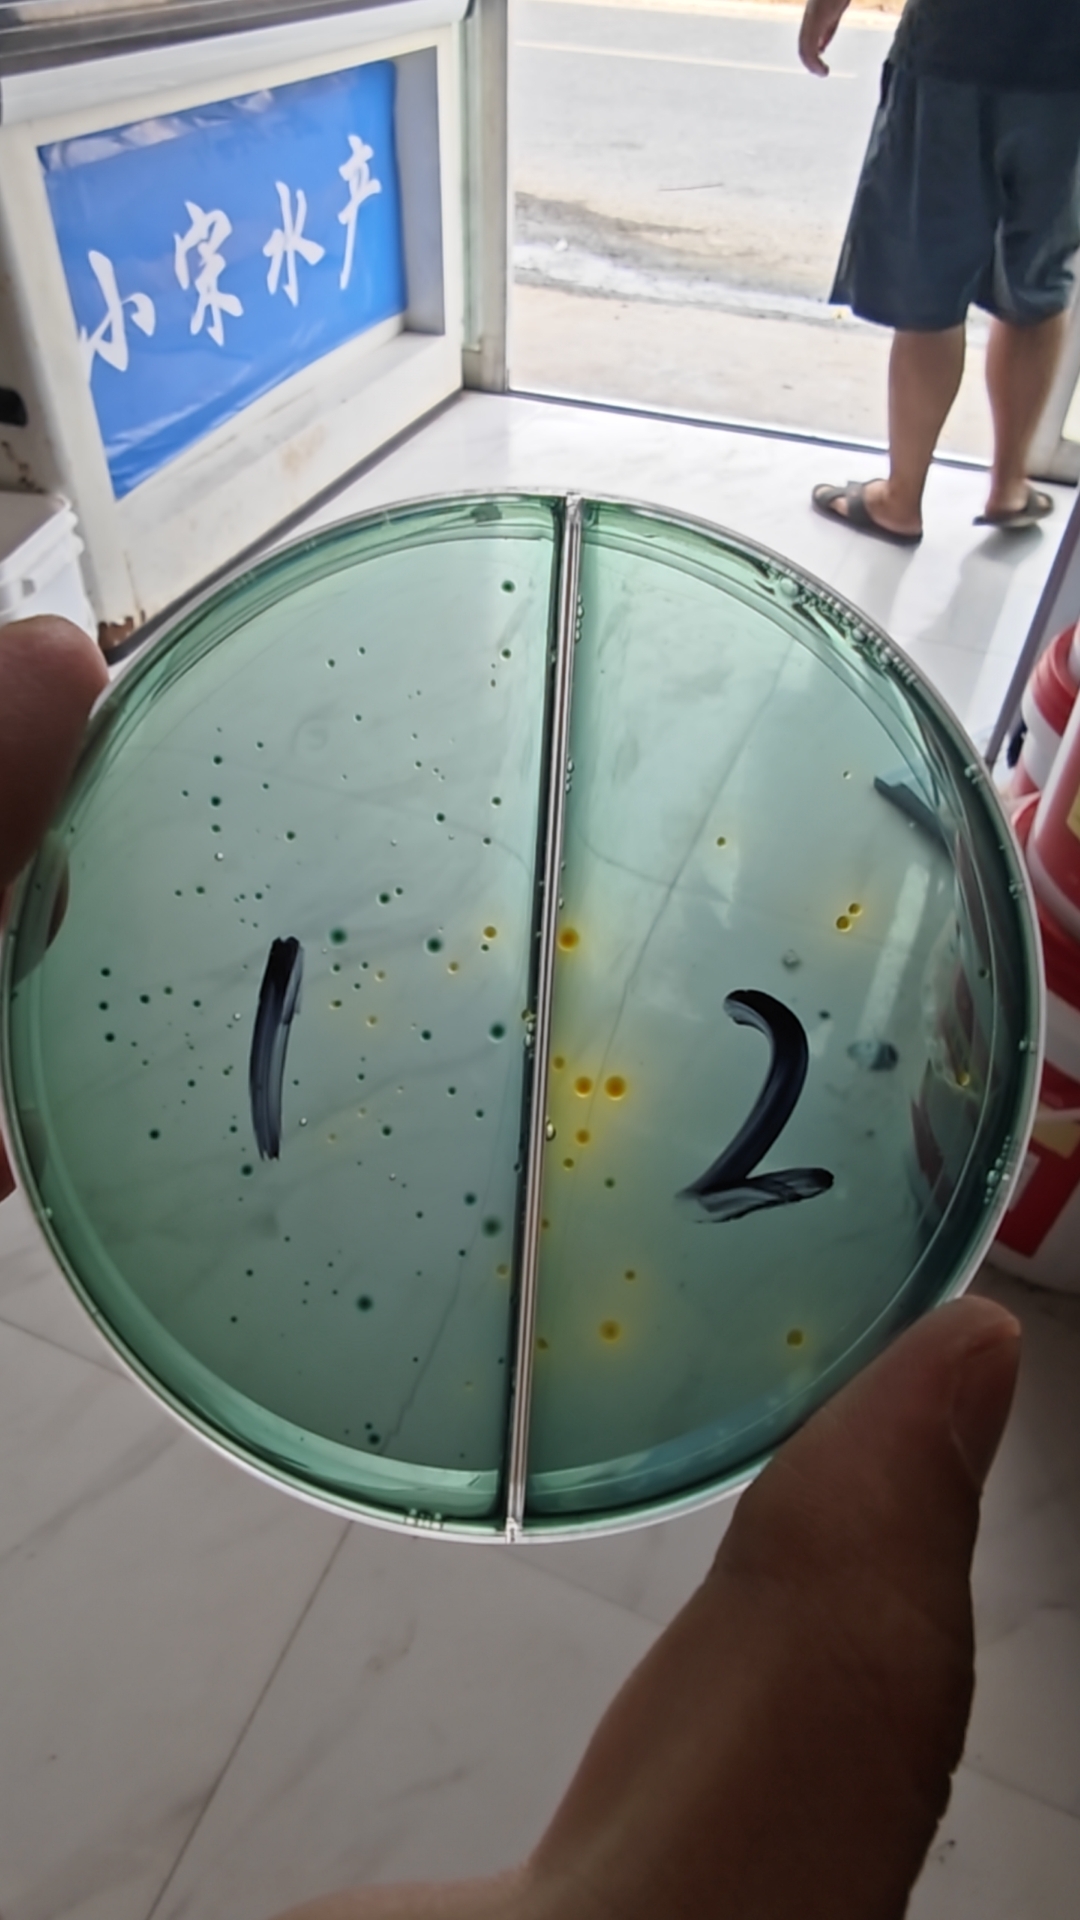
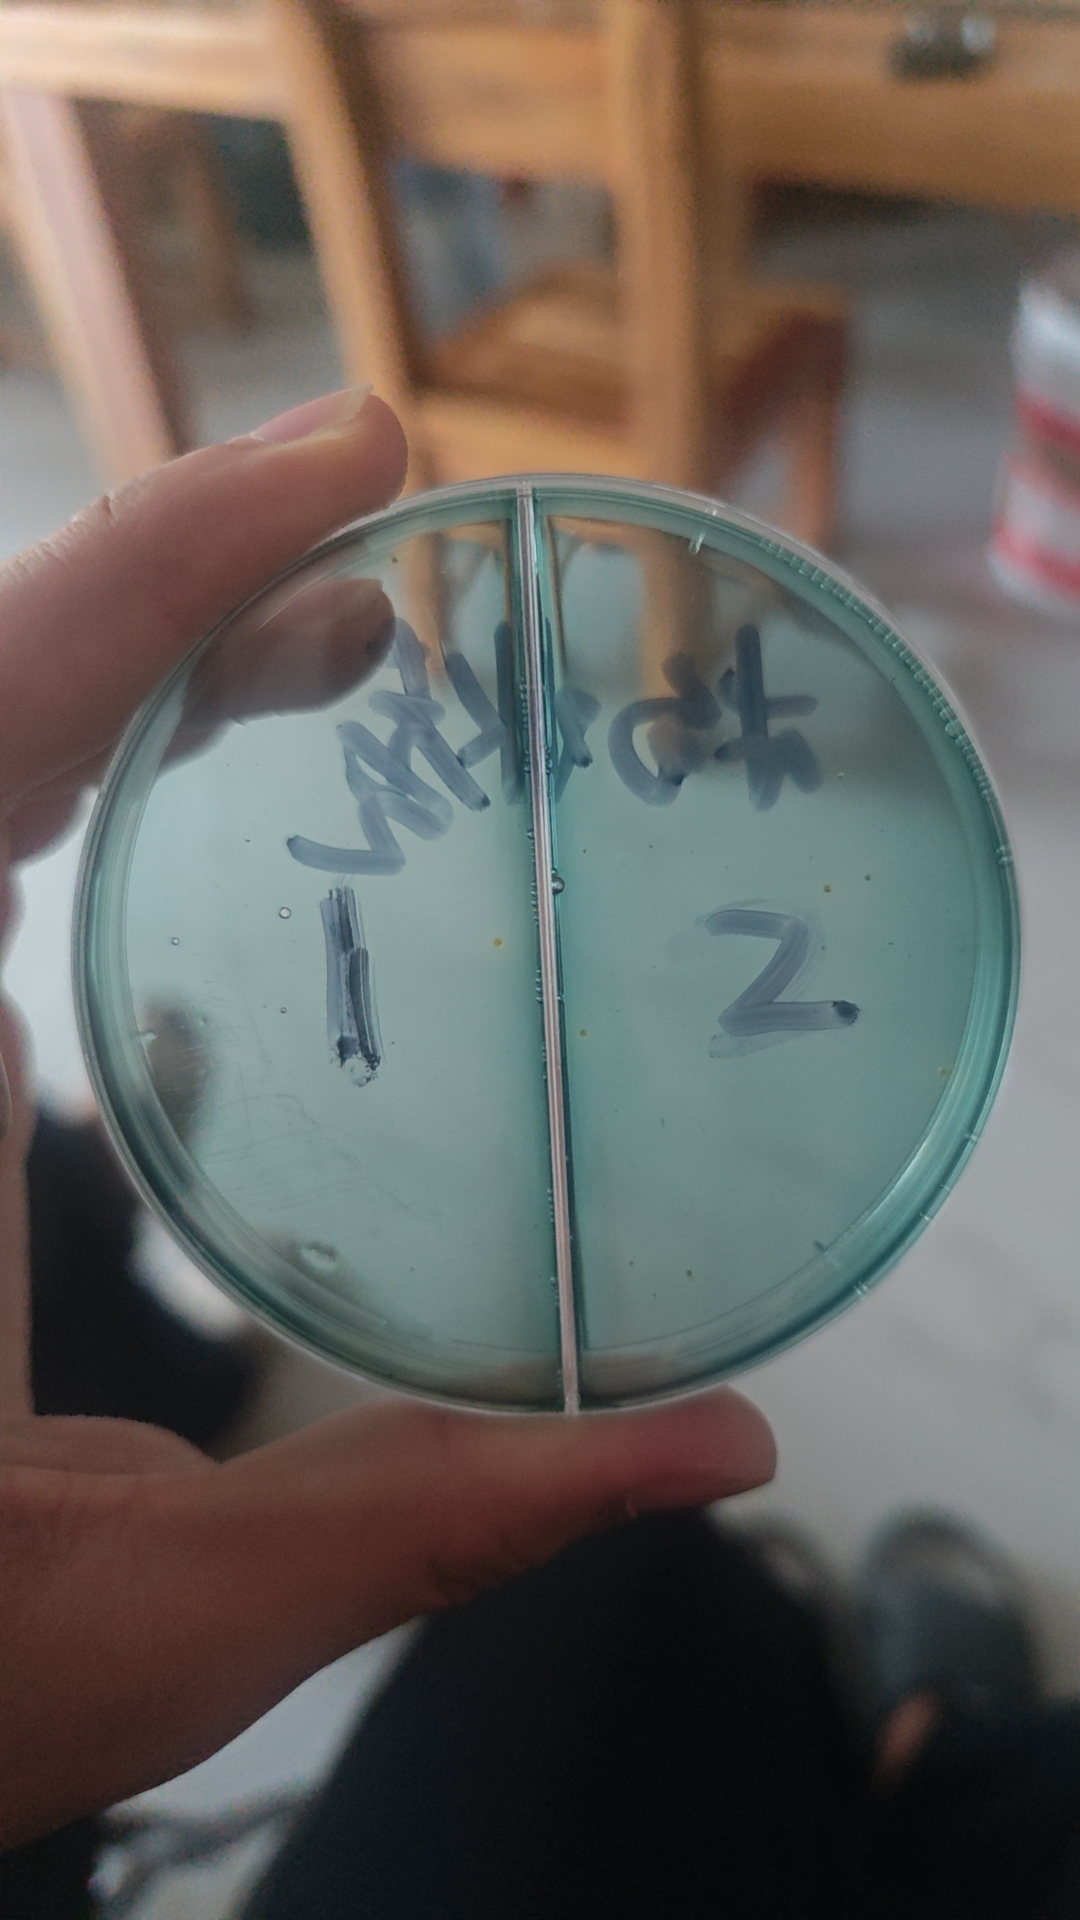

弧菌病主要由弧菌大量爆发、池底环境恶化以及对虾体质差共同导致的,是对虾养殖过程中最常见、危害对虾整个养殖周期的细菌性疾病。弧菌的感染途径主要是经口传播,其次是通过体表创伤和鳃进入体内弧菌通过主动粘附在消化道或创伤口,破坏表皮,进入体内,导致炎症和组织的溃烂、坏死或萎缩等。
地点;杭州萧山钱塘区
时间;9月3日至9月5日
面积;25亩外塘,
水深;2米
品种;南美白对虾
近期该养殖户来做平板检测,发现绿弧菌偏多。
建议处理方法中仁二氧化氯,2亩每包

第二天使用50%过硫酸氢钾复合盐泡腾片1包一亩

第三天补充活菌。使用后效果
本文供稿:孔德帅,张鹏
编辑审核:张传宝,臧学运

